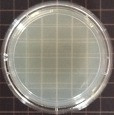
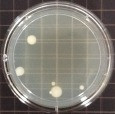
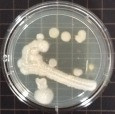
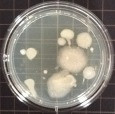
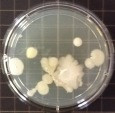
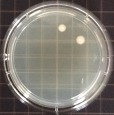
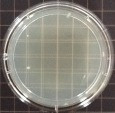
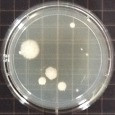
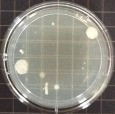
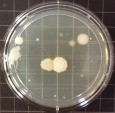
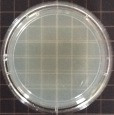
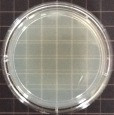
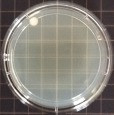
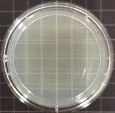
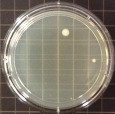

プロジェクト実行者
ストーリー
《《 薬剤不使用。特許技術のウィルシュータ 》》

ウィルシュータは、【亜鉛】が入っている水です。亜鉛のサプリメントもあり、赤ちゃんは母親の胎内にいる時から摂取を初め、離乳食にも添加されている重要なミネラルです。
そして無機金属である亜鉛は銀と同じく、高い抗菌性と抗ウイルス性、消臭力を持ちます。アルコールや薬剤に頼らない全く新しい抗菌液、このウィルシュータを使ったウエットタオルを紹介させて頂きます。

《《 亜鉛がもつ収れん作用の効果 》》
現在、広く出回っているノンアルコールのウエットタオルですが、除菌成分に使われるのは全て薬剤や化学溶剤です。これらの原液は大抵が毒劇物(だから菌が死ぬのですが)で、人体に本当に安全と言えるものではありません。除菌力が高いものは独特の臭いがし、肌荒れ、ベタつきを感じる人も少なくありません。
亜鉛には収れん作用(肌細胞の修復を助け、引き締める効果)があり、ウィルシュータは、今まで諦めていた使用感の欠点が全てカバーできます。今までのウエットタオルとはサラサラ感が全然違います。

最近はニュースで取り上げられることもありますが、医療業界では消毒薬の危険性や、薬に頼りすぎることが新たな耐性菌を生んでいる問題があります。そこに貢献したく誕生したウィルシュータは、現在、医療機関や介護施設で、感染問題への意識が高い方々の間で既にご採用いただいており、使いやすさでご評価をいただいています。

《《 保存も安全!今年1月に防災製品等推奨商品に認定されました 》》
薬に頼っていないので劣化や腐敗の恐れが極めて低い点も高く評価され、備蓄用として市役所でのご採用をきっかけに、一般の方々が身近で安全に備えられるものを作りたいと思うに至ったことが、今回の新商品開発のきっかけです。

一般社団法人 防災安全協会が認定する「防災製品等推奨品」は、災害時に有効に活用出来て安全と認められる防災用品に対して推奨する制度です。消防、防災、災害医療などの有識者により構成された審査を通過し、推奨認定されると、防災製品等推奨品マークの提示が認められます。
《《 非常時の不衛生は、想像以上のストレス 》》
東日本大震災では、医療機関用に展開している大容量のウエットタオルを2000個支援し、大変喜んでいただきました。日本人はやはり綺麗好きなので、いくらあっても足りないアイテムだと被災地のスタッフさんにも聞きました。
日本は世界的な地震大国ですが、非常時は大地震だけではありません。水が使えない時はお風呂に入れないだけでなく、身体を置くスペースや食器ひとつすら、清潔に保つことが困難です。いざという時、また、普段使いとしても、皆様の予想以上の働きができるウィルシュータのウエットタオルを、ご家庭に、職場に、是非お備え下さい。
仕様
成分:水、亜鉛、有機酸、防腐剤(全て国産)
布生地:ポリエステル、レーヨンのプレーン生地
布サイズ:15×30cm・大判
保証期間:未開封に限りご購入より2年
使用期限:開封、未開封に関わらずご購入より2年
除菌力と持続力の比較
医療と看護のプロに認めて頂いたデータが沢山あるのですが、シンプルでわかりやすいものを掲載しています。除菌した部分を、時間の経過を追って衛生状態を調べたものです。
①アルコール消毒剤(薬局方エタノール80%)←国も認めている消毒剤です。
1分後 10分後 60分後 120分後 24時間後

②ノンアルコール消毒剤(標準※第四級アンモニウム塩類)←現在ノンアルコールタイプのウエットタオルに一番多く使われているのはこの薬剤です。
1分後 10分後 60分後 120分後 24時間後

③ウィルシュータ
1分後 10分後 60分後 120分後 24時間後

安全性試験
〇急性経口毒性試験:5000mg/Kg以上
〇皮膚感作性試験:皮膚感作性を有しない(←遅延型アレルギーのテストです)
〇眼刺激性試験:「無刺激物」の範疇にある
〇変異原性試験:突然変異誘起性陰性(←発ガン性はないという意味です)
〇皮膚貼付試験:準陰性(←敏感肌でも安全という意味です)
FAQ
Q.子供にも使えますか?
小児薬のような試験は受けておりませんが、病院では抵抗力の弱い様々な年代の方にお使い頂いており、今のところ、肌トラブル等の報告は一件も受けておりません。亜鉛の特徴については冒頭に述べたとおりで危険なものではありません。
Q.成分の亜鉛で金属アレルギーを起こしませんか?
作用機序や構造の説明はここでは省略いたしますが、起こさないように作ってあります。自信の安全性ですのでご安心のうえお使いください。
Q.成分に防腐剤の記述があるので安全性が気になります。
ウエットタオル、除菌消臭剤類に関しては、表記が無くても全ての商品に防腐剤が必ず使われている(主に黒カビ予防)ことをまずご理解下さい。ウィルシュータに使用する防腐剤は、化粧品への添加が認められているもので、使用量は化粧品の使用基準を大きく下回り、分析機関に出しても検出されないほどの微量です。安全性試験は高い評価でクリアしておりますのでご安心ください。
Q.メイク落としに使えますか?
お化粧は、落とすという観点から申しますと頑固な油汚れです。ウィルシュータは水ですので、メイク落としには向きません。メイク落としには強力な薬剤が含まれており、拭いたあと放置しておくのはお肌に良くありませんので、最後に洗い流せない時は、ウィルシュータのウエットタオルでメイク落としの成分を拭き取られることをお勧めします。
Q.一枚でどれくらいの範囲が拭けますか?
対象や状態にもよりますが、全身を拭くのに成人で2~3枚、床でしたら一枚で一畳分は拭けます。
Q.体臭も消せますか?
個人差はありますが、①尿臭(アンモニア)、②加齢臭や足の臭いの原因成分(イソ吉草酸)、③魚臭(トリメチルアミン)には、効果と優位性を確認済みです。ニオイ菌を不活性化して消臭するので、シャンプーなどの香りは消しません。一般的な汗臭さにも効果がありますが、ワキガは難しいと考えております(未試験)。
Q.車に積んでおいても大丈夫ですか?
亜鉛は温めても亜鉛のままですので大丈夫です。シャワーが出来ないキャンプやアウトドアにも向いています。あまり高温状態が続くとバケツが変形する恐れがありますので、真夏に車内の積みっぱなしにはご注意下さい。
リターン品一覧
★4800円:ウィルシュータ防災・非常用ウエットタオル
★5300円:ウエットタオル大小セット(①ウィルシュータ防災・非常用ウエットタオル ②携帯用ウエットタオル)
★13000円:安全防災3点セット(①ウィルシュータ防災・非常用ウエットタオル ②携帯用ウエットタオル ③他の座布団を使いたくなくなる座布団)
★20000円:安全防災3点セット座布団ロング(①ウィルシュータ防災・非常用ウエットタオル ②携帯用ウエットタオル ③他の座布団を使いたくなくなる座布団ロングサイズ
★26000円:お友達とシェアセット(ウィルシュータ防災・非常用ウエットタオル6個セット)
★22500円:(数量限定)お友達とシェアセット(ウィルシュータ防災・非常用ウエットタオル6個セット)
他の座布団を使いたくなくなる座布団とは
天然ゴム100%のクッションです。天然ゴムの感触は、知れば誰もが魅了されます。そしてなかなかヘタりません!インドアでもアウトドアでも対応可。フィルムはウィルシュータが練り込んであり永久抗菌状態。汚れても水拭きで常に清潔です。


弊社は日本の病院のベッドに初めて天然ゴムのマットレスを広めた企業です。
抗菌効果試験一覧 ・・・興味のある方はご覧ください。
・A型インフルエンザ(H1N1):抗ウイルス効果試験◎
(㈶北里環境科学センター)
・ネコカリシウイルス:抗ウイルス効果試験〇(㈶北里環境科学センター)
・カンピロバクター:MIC・MBC◎ (㈶北里環境科学センター)
・クロストリジウム(芽胞):MIC◎ (㈶北里環境科学センター)
・黄色ブドウ球菌:MIC◎(㈶日本化学繊維検査協会生物試験センター)
・大腸菌:MIC◎(㈶日本化学繊維検査協会生物試験センター)
・サルモネラ菌:MIC◎(㈶日本化学繊維検査協会生物試験センター)
・肺炎桿菌:MIC◎(㈶日本化学繊維検査協会生物試験センター)
・MRSA:MIC◎(㈶日本化学繊維検査協会生物試験センター)
・緑膿菌:MIC◎(㈶日本化学繊維検査協会生物試験センター)
・メタロβラクタマーゼ産生菌:MIC◎(㈶北里環境科学センター)
・鳥インフルエンザ(H5N3):抗ウイルス効果試験◎(鳥取大学)
・鳥インフルエンザ(H5N1):抗ウイルス効果試験10分◎
・ 〃 : 〃 有機物10%存在下◎
・ 〃 : 〃 一カ月乾燥後◎
((独)農業・食品産業技術総合研究機構 動物衛生研究所)
・鳥インフルエンザ(H7N7):抗ウイルス効果試験◎(京都産業大学)
他多数試験済
※抗菌効果・感染低下率 〇=90%以上 ◎=99,99~100%
開発とMakuakeとのご縁
弊社は1966年、クリーニング会社として誕生し、滋賀県で初めて、全国でも殆ど展開されていないクリーニング営業店のチェーン化を開始しました。20年後、基準寝具部門の開設によって医療現場の様々な苦労や実態を知り、ここでもやはり、まだ他がやっていないことを追求して、東南アジアでゴムの木を植え、二酸化炭素を吸収し続けるゴムの樹液を採取して、スリランカの自社工場で天然ゴム100%のマットレスを生産しています。ゴムの木と同様、このマットレスも約10年利用された後、再び土に戻ります。人にも地球にも優しい事業に強くこだわっております。
薬ではなく金属イオンで除菌をするウエットタオルは既に多くの医療機関や福祉施設でご愛用いただいていますが、現場の皆様に、「こんなに良いものを何で一般販売しないの?」とのお声を結構頂いておりました。従来のものとは何から何まで違う抗菌液の為、病院や施設では直接説明やプレゼンテーションをさせていただくので、「値段より品質」を理解してご採用いただけるのですが、一般向けとなると、大企業のような広告宣伝費もないし、安い他製品との違いをどう伝えればいいのかよく分かりませんでした。
まさに暗中模索の時に、ある方からのご紹介でMakuakeさんとご縁をいただき、今回、初めてクラウドファンディングに出品させていただく運びとなりました。準備期間においては沢山の方々に助けていただき、心より感謝いたしております。
サポーターからの応援コメント
文章のトップに戻る
応援購入する
このプロジェクトはAll in型です。目標金額の達成に関わらず、プロジェクト終了日の2017年06月07日までに支払いを完了した時点で購入が成立します。
【10%OFF】防災・非常用ウエットタオル
4,800円(税込)
(更新日:2017年08月01日)
■ウィルシュータ防災・非常用ウエットタオル 1個
★販売予定価格:5000円(税別・送料別)
→Makuake記念価格【税込10%OFF・送料無料】:4800円
【20%OFF】ウエットタオル大小セット
5,300円(税込)
(更新日:2017年08月01日)
■ウィルシュータ防災・非常用ウエットタオル 1個
■ウィルシュータ防災・非常用ウエットタオル携帯用 1個
★販売予定価格:6200円(税別・送料別)
→Makuake記念価格【税込20%OFF・送料無料】:5300円
・完成品の防災・非常用ウエットタオルに、携帯サイズの110枚入りを1つおつけします。携帯用はやわらかメッシュ素材です。
【20%OFF】安全防災3点セット
13,000円(税込)
(更新日:2017年08月01日)
■ウィルシュータ防災・非常用ウエットタオル 1個
■ウィルシュータ防災・非常用ウエットタオル携帯用 1個
■他の座布団を使いたくなくなる座布団 1枚
★販売予定価格:15200円(税別・送料別)
→Makuake記念価格【税込20%OFF・送料無料】:13000円
★他の座布団を使いたくなくなる座布団とは・・・
・高級品専門のネットや通販カタログでしか見かけないかも知れませんが、天然ゴム100%のクッションで出来た座布団です。ウレタンクッションや化繊ワタとの違いは、一度使えば誰もがわかる極上の感触です。
・座布団サイズ:縦40×横40×厚さ4cm 現行販売価格:9000円(税別・送料別)
【20%OFF】安全防災3点セット(ロング座布団)
20,000円(税込)
(更新日:2017年08月01日)
■ウィルシュータ防災・非常用ウエットタオル 1個
■ウィルシュータ防災・非常用ウエットタオル携帯用 1個
■他の座布団を使いたくなくなる座布団ロングサイズ 一枚
★販売予定価格:23200円(税別・送料別)
→Makuake記念価格【税込20%OFF・送料無料】:20000円
★座布団ロングサイズは、背もたれの部分もカバーします。小さいお子様の衛生マットレスにも最適です。
・サイズ:縦83×横40×厚さ4cm 現行販売価格:17000円(税別・送料別)
【Makuake特別割引・先着15名】お友達とシェアセット数量限定
22,500円(税込)
(更新日:2017年08月01日)
■ウィルシュータ防災・非常用ウエットタオル 6個
★販売予定価格:30000円(税別・送料別)
→Makuake特別割引【税込30%OFF・送料無料】:22500円
・数量限定での特別割引です。先着15名様でお願いします。
【20%OFF】ご家族・お友達とシェアセット
26,000円(税込)
(更新日:2018年03月13日)
■ウィルシュータ防災・非常用ウエットタオル 6個
★販売予定価格:30000円(税別・送料別)
→Makuake記念価格【税込20%OFF・送料無料】:22000円
「Makuake(マクアケ)」は、実行者の想いを応援購入によって実現するアタラシイものやサービスのプラットフォームです。このページは、 プロダクトカテゴリの 「安全で高機能!今までになかったタイプの防災・非常用ウエットタオル」プロジェクト詳細ページです。